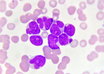

Doctors at Hyderabad hospital perform rare cardiac procedure
IANS | Jan 20, 2021
New drug combination may help treat acute myeloid leukemia
IANS | Jan 20, 2021
Fake Johnson and Johnson sutures racket busted in Mumbai
IANS | Jan 20, 2021
50% patients in need of early liver transplant died during pandemic
IANS | Jan 20, 2021
Study finds that fatty acid may combat multiple sclerosis
ANI | Jan 20, 2021
Dr. Suresh Rasaily, first to be inoculated, feels good after vaccination
UNI | Jan 20, 2021
Gujarat: Doctor, 3 others held for COVID-19 insurance fraud
PTI | Jan 19, 2021
Most read this week